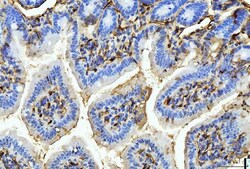
Invitrogen FABP4 Monoclonal Antibody (10E12) 100 &mu;g | Buy Online | Invitrogen&trade; | Fisher Scientific

Learn More
Invitrogen™ FABP4 Monoclonal Antibody (10E12)


Description
Adding 0.2 mL of distilled water will yield a concentration of 500 μg/mL. Immunogen sequence is identical to the related mouse and rat sequences. Positive Control - WB: human RT4 whole cell, human HL-60 whole cell, rat thymus tissue, mouse thymus tissue. IHC: human renal clear cell carcinoma tissue, human gall bladder adenosquamous carcinoma tissue, human gastric cancer tissue, human lymphadenoma tissue, rat intestines tissue, mouse intestines tissue, mouse intestines tissue. Store at -20°C for one year from date of receipt. After reconstitution, at 4°C for one month. It can also be aliquotted and stored frozen at -20°C for six months. Avoid repeated freeze-thaw cycles.

Specifications
Specifications
| Antigen | FABP4 |
| Applications | Immunohistochemistry (Paraffin), Western Blot |
| Classification | Monoclonal |
| Clone | 10E12 |
| Concentration | 500 μg/mL |
| Conjugate | Unconjugated |
| Formulation | PBS with 4mg trehalose and no preservative |
| Gene | FABP4 |
| Gene Accession No. | P04117, P15090, P70623 |
| Gene Alias | 3T3-L1 lipid-binding protein; 422/aP2; adipocyte fatty acid binding protein; Adipocyte lipid binding protein; adipocyte lipid-binding protein; adipocyte protein aP2; adipocyte-type fatty acid-binding protein; AFABP; A-FABP; ALBP; ALBP/Ap2; Ap2; epididymis secretory protein Li 104; FABP4; fatty acid binding protein 4; Fatty acid binding protein 4 adipocyte; fatty acid binding protein 4, adipocyte; fatty acid-binding protein 4; Fatty acid-binding protein, adipocyte; HEL S 104; HEL-S-104; Lbpl; myelin P2 protein homolog; P15; P2 adipocyte protein; Protein 422 |
| Show More |
By clicking Submit, you acknowledge that you may be contacted by Fisher Scientific in regards to the feedback you have provided in this form. We will not share your information for any other purposes. All contact information provided shall also be maintained in accordance with our Privacy Policy.